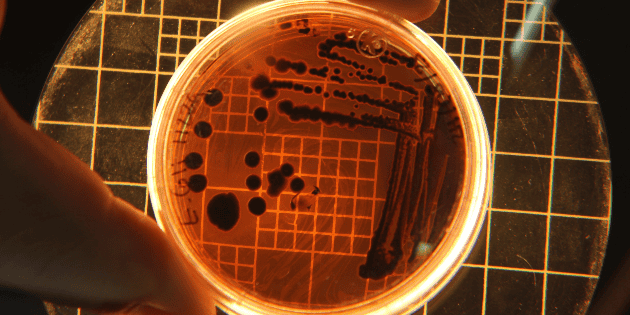

Consideradas “eslabones perdidos” de la evolución hasta su hallazgo en 2015, las arqueas Asgard son las protagonistas de la expedición oceanográfica que, integrada por 26 científicos de ocho países, comenzaron a navegar desde este pasado jueves por las aguas de Uruguay en busca de nuevas respuestas sobre el origen de la vida compleja.
En 1977, un descubrimiento científico marcó un antes y un después: un equipo liderado por el microbiólogo Carl Woese identificó un nuevo dominio biológico, Archaea, que, incluido dentro del superreino Prokaryota, pasó a formar —junto con Bacteria y Eukarya— una de las tres ramas del “árbol de la vida”.
Según la teoría endosimbiótica formulada en 1967, los biólogos concluyeron que uno de los organismos que se unieron para dar origen a las células eucariotas —las de plantas y animales— fue una alfa-proteobacteria, mientras que el otro debía ser una arquea. Sin embargo, identificar a esta última resultó un verdadero desafío.
Asgard, el eslabón perdido
Como explica la bióloga Cecilia Alonso en una entrevista con EFE, durante “muchísimo tiempo” se consideró a esta arquea como “el eslabón perdido” de la evolución.
Recién en 2015, una expedición en el campo hidrotermal Castillo de Loki, en el Atlántico Norte, descubrió las “lokiarqueas”, dando por concluida la búsqueda.
Bautizadas “arqueas Asgard” por la mitología nórdica —Loki da nombre a la zona donde fueron encontradas—, su particularidad, detalla Alonso, radica en que “poseen características asociadas a estructuras que normalmente solo se encuentran en células eucariotas”.
Lee: México es “un país herido por violencias múltiples”: Iglesia Católica
“Esas estructuras son los citoesqueletos, unos tubitos muy finos que las células tienen en su interior, responsables de darles forma y permitirles, por ejemplo, generar proyecciones de su cuerpo, como pequeños brazos o patas”, añade.
Analizar sus metabolismos, cómo construyen sus células y “qué potencial tienen” constituye, según la bióloga, el “objetivo central” de la expedición que las buscará en aguas uruguayas, donde un observatorio microbiano instalado en 2014 en la Laguna de Rocha (sureste) ya ha registrado su presencia.
“¿Por qué aquí? Bueno, lo que se ha observado es que suelen preferir ambientes muy ricos en nutrientes y materia orgánica, y nuestro mar territorial es un ambiente altamente productivo”, afirma Alonso.
Secuenciar a bordo
A bordo del buque Falkor (Too) del Instituto Schmidt Ocean, Alonso será la única latinoamericana al frente del equipo, que coordinará junto con investigadores de las universidades de Texas y California, y en el que participan especialistas de Austria, Canadá, India, Reino Unido, República Checa y México.
Según explica, la campaña durará 22 días, durante los cuales se recorrerán once estaciones. La secuenciación masiva metagenómica para analizar el material genético de las arqueas se realizará directamente a bordo.
“La idea es ir haciendo los descubrimientos en tiempo real. Si las encontramos en altas concentraciones en algunos de estos puntos —como esperamos—, se pondrá en marcha toda una serie de experimentos. Por eso hay pocas estaciones, mucho trabajo a bordo y bastante tiempo dedicado a cada una”, señala.
Mira: Peso mexicano aporrea al dólar en el arranque de este 11 de noviembre
Además de secuenciar, los investigadores desarrollarán tareas que abarcan desde observar con “ultra resolución” las estructuras internas de las células hasta estudiar procesos a gran escala, como los del ecosistema. También participarán químicos dedicados al análisis del agua y del sedimento.
“Hay especialistas que llevarán un microscopio de fluorescencia de alta potencia para estudiar cómo se sintetizan las membranas de estas arqueas y comprender cómo funcionan y cómo, por ejemplo, pudieron haber abrazado y englobado a la otra bacteria con la que se asociaron”, ejemplifica.
*Mantente al día con las noticias, únete a nuestro canal de WhatsApp.
AO
Cortesía de El Informador
Dejanos un comentario: